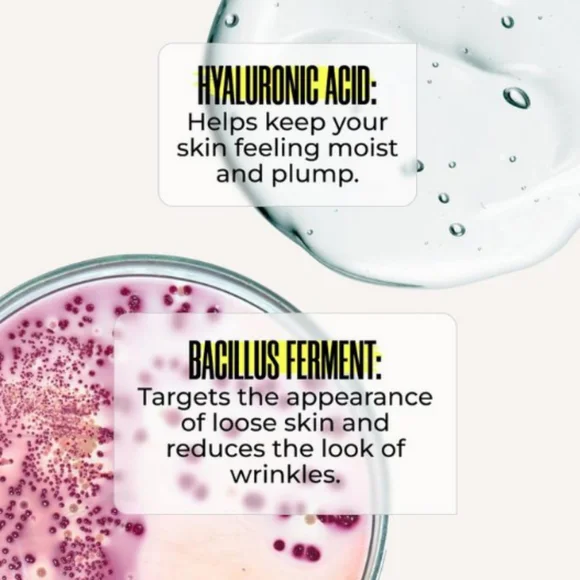
img

*** FULL SIZE ***MAELYS RE-SOLVE AGE-DEFYING BODY SERUM.3.5 OZ.FULL DESCRIPTION IN PHOTOS.BRAND NEW IN SEALED BOX.
Spedizione gratuita per ordini superiori a $47.

*** FULL SIZE ***MAELYS RE-SOLVE AGE-DEFYING BODY SERUM.3.5 OZ.FULL DESCRIPTION IN PHOTOS.BRAND NEW IN SEALED BOX.